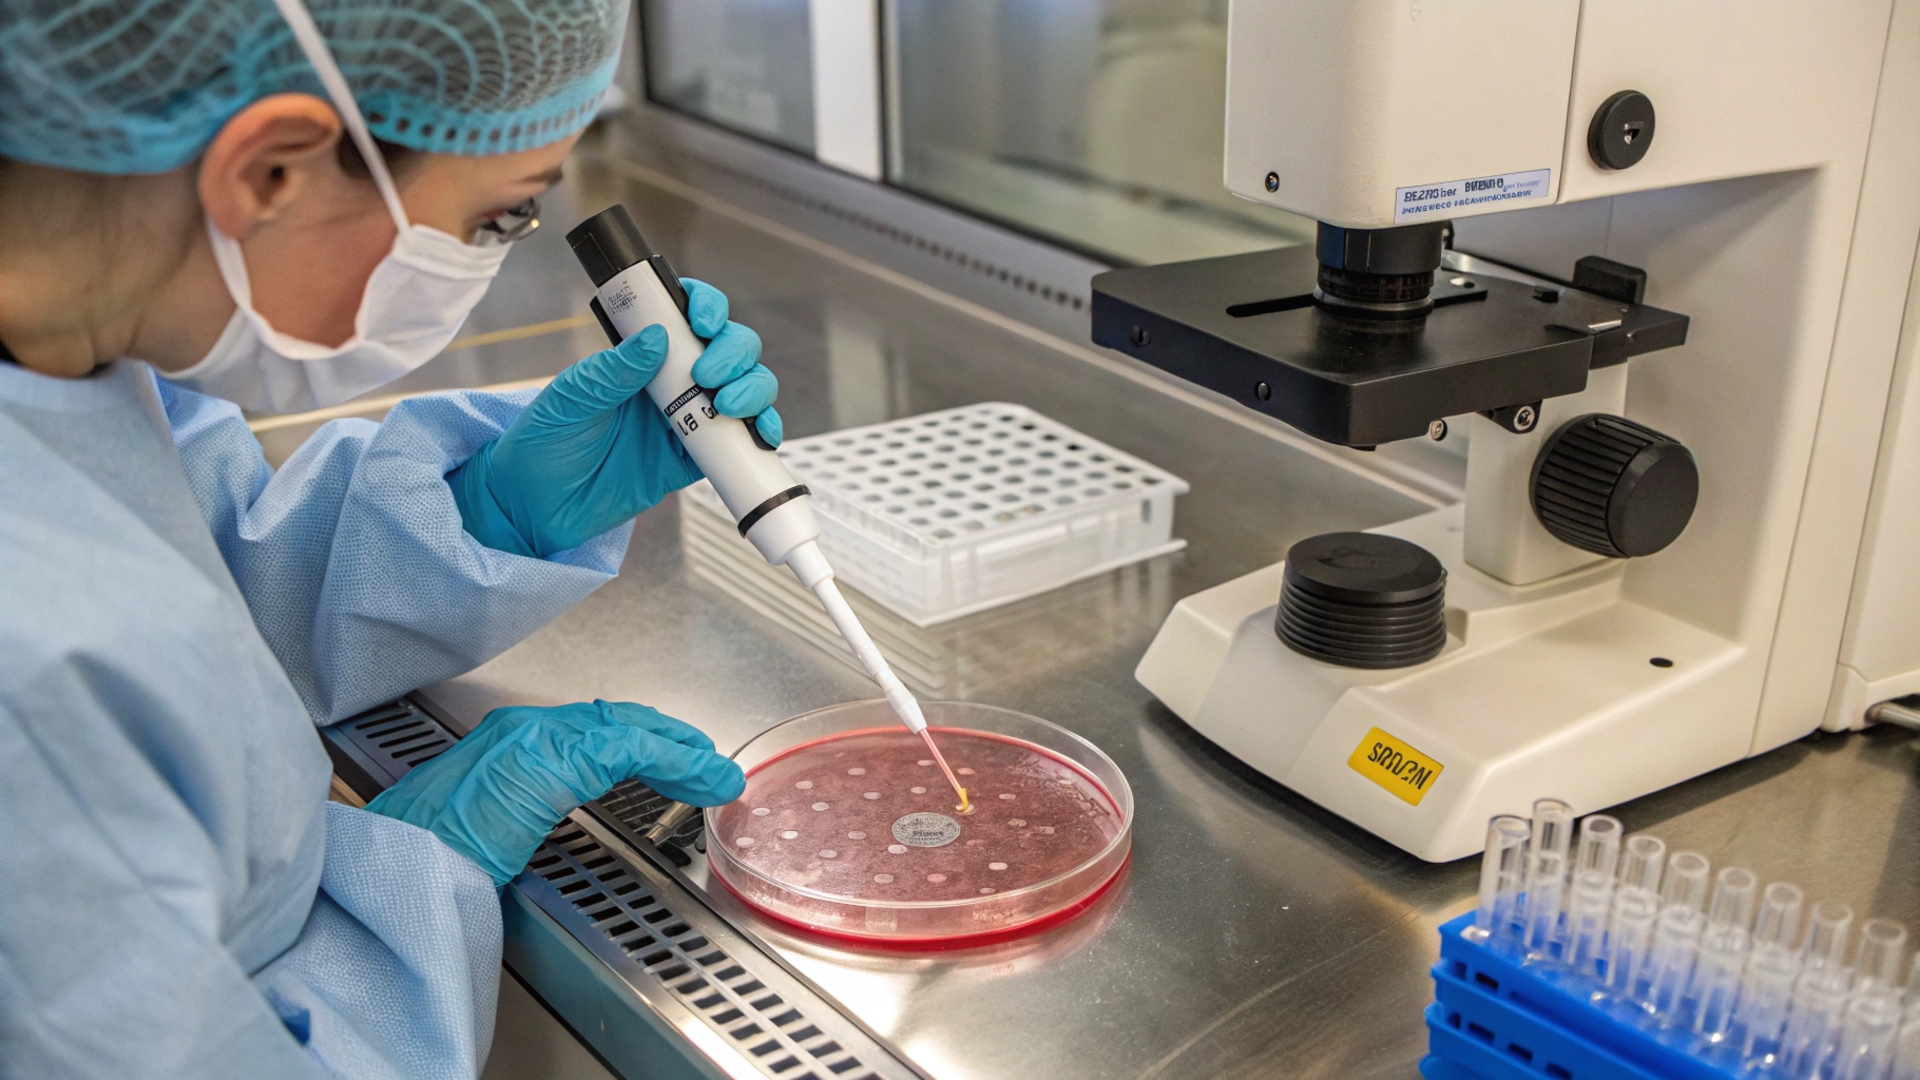

Appelez
+212 0522274820+212 0522276640
+212 661134182
 Medic Interface Maroc
Medic Interface Maroc
 Medic Interface Maroc
Medic Interface Maroc
Les étapes de la Procréation Médicalement Assistée ou PMA:
1. Consultation initiale: Elle consiste à évaluer la situation médicale du couple et sa capacité à procréer( âge).Un bilan est fait pour juger de la cause de l'infertilité.
2. Le choix de la technique de PMA: dépend du résultat du bilan: Insémination artificielle IA,Fécondation In Vitro FIV ou autres…
3. Préparation au traitement: Selon la technique choisie des injections hormonales sont alors administrées pour stimuler les ovaires.
4. Ponction ovarienne: Les ovocytes matures sont prélevés par voie vaginale lors d'une intervention réalisée sous anesthésie.
5. Fécondation: Les ovocytes sont fécondés au laboratoire pour obtenir un ou deux embryons.
6. Implantation de l'embryon dans l'utérus de la femme demandeuse.
7. Suivi de grossesse: Un test de grossesse positif deux semaine après traduit la réussite de la tentative,la grossesse devient précieuse et sera suivie de façon attentive et rapprochée.
Encadrant ces tentatives très éprouvantes un accompagnement psychologique peut être bénéfique le long de la grossesse.
Des centres spécialisés choisis pour vous en fonction de leurs agréments ,leur compétences et leur notoriété vous permettent de tenter la grossesse que vous désirez avec le maximum de chance de réussite.
Téléphone
+212 0522274820
+212 0522276640
+212 661134182
contact@medicinterfacemaroc.com
Adresse
12, Boulevard d'Anfa, Casaclanca - Maroc
© Medic Interface Maroc. Tous droits réservés.
Conçu par modiom Tech
